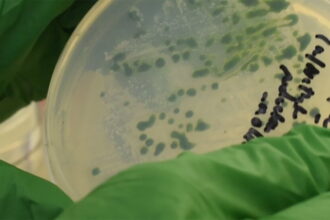
recent algae discovery كيف يمكن للطحالب أن تعزز إنتاج الوقود الحيوي؟ مجلة نقطة العلمية

مشروع مات قبل أن يولد.. عملة فيسبوك المشفرة في طريقها للنهاية
تستكشف رابطة "ديم" التي أنشأتها "فيسبوك" لإدارة العملة…
بواسطة
نجاح عملية زرع كليتين من خنزير معدل وراثيا في متلق بشري ميت دماغيا
تم زرع كليتين من كلى الخنازير المعدلة وراثيًا…
بواسطة
أكثر من وفيات الملاريا .. مقاومة المضادات الحيوية تقتل الملايين
حذر مسؤولو الصحة في المملكة المتحدة مؤخرًا من…
بواسطة
إنستجرام يختبر إدخال الإشتراكات المدفوعة مقابل المحتوى الحصري
يمكن لمنشئي المحتوى الاختيار من نطاق سعر للمحتوى…
بواسطة
تحول موسم الإنفلونزا إلى موسم “إنفلونزا رونا” كل شتاء!
تحول موسم الإنفلونزا إلى موسم كوفيد وأنفلونزا -…
بواسطة
دراسة تكتشف أن الجينات تلعب دورًا في فقد حاسة الشم مع الإصابة بكورونا
يزيد عامل الخطر الوراثي من احتمال أن يفقد…
بواسطة
محطمًا الرقم القياسي.. جهاز استشعار يسجل إشارات الدماغ بتفصيل غير مسبوق
توفر الشبكة الرفيعة والمرنة منظورًا تفصيليًا للغاية لأجزاء…
بواسطة
فقر الدم الفضائي يجعل الدم البشري يدمر نفسه ويحير العلماء!
تسمى هذه الظاهرة الغريبة بفقر الدم الفضائي، وتشير…
بواسطة
مدربة لياقة بدنية تجيب: متى سترى نتائج التمرينات على جسدك؟
ربما لا تقتصر دوافع التمرين لديك على الشكل…
بواسطة
دلتاكرون.. هل نحن بصدد متحور جديد أم خطأ تقنيّ؟
أثار الإعلان القلق خلال عطلة نهاية الأسبوع بعد…
بواسطة
ثغرة في متصفح سافاري تكشف سجل التصفح والمعلومات الشخصية
في بعض الأحيان، يتضمن ذلك معلومات فريدة خاصة…
بواسطة
دراسة: تدخين السجائر الإلكترونية يرتبط بزيادة أعراض كورونا
يعتقد الباحثون أن الالتهاب الناجم عن الفيروس التاجي…
بواسطة
شاهد إطلاق أكثر من 40 قمرا صناعيا للإنترنت من شركة “Starlink” !
سيطلق صاروخ SpaceX أسطولًا جديدًا من أقمار الإنترنت…
بواسطة